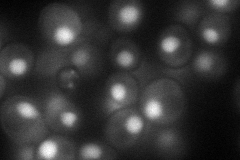
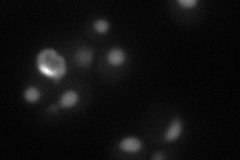
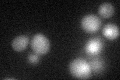

View description
Zinc-regulated transcription factor; binds to zinc-responsive promoters to induce transcription of certain genes in presence of zinc, represses other genes in low zinc; regulates its own transcription; contains seven zinc-finger domains
Localization:
Intensity:
Fold change:
Significance:
-
C’ GFP library in SD

nucleus19.71 -
N' NOP1pr-GFP in SD
nucleus71.5519 -
N' TEF2pr-mCherry in SD
nucleus29.8105 -
N' NATIVEpr-GFP in SD

nucleus20.4577 -
N' TEF2pr-VC and Cyto-VN in SD

nucleus33.0172 -
C’ GFP library in SD+DTT
nucleus18.080.91No -
C’ GFP library in SD+H2O2

nucleus18.350.93No -
C’ GFP library in Starvation Media

nucleus16.430.83No -
C’ GFP library on the background of Pup2-DaMP

nucleus -
C’ GFP library on the background of CCT mutant

nucleus22.05811.11857No
